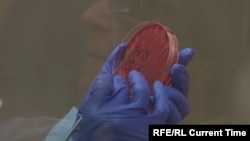

Лаборатория Лугара в Тбилиси – исследовательский центр общественного здравоохранения. Это учреждение регулярно попадает в топ российских новостей о Грузии: его называют "центром по созданию бактериологического оружия" и "базой опасных вирусов".
Грузинский исследовательский центр был создан по инициативе бывшего сенатора Ричарда Лугара, который работал над программой уничтожения оружия массового поражения в странах СНГ, и носит его имя, поэтому в публикациях часто говорится об "американском следе" в деятельности лаборатории.
В середине апреля лабораторию в контексте отравления в Великобритании бывшего офицера ГРУ Сергея Скрипаля и его дочери Юлии упомянула официальный представитель российского МИДа Мария Захарова. Она назвала работу лаборатории "масштабной медико-биологической деятельностью Пентагона" и заявила, что это вызывает у Москвы "особое беспокойство".
Что на самом деле представляет из себя лаборатория и стоит ли ее бояться? Корреспонденты телеканала "Настоящее Время" лично побывали внутри и пообщались с ее работниками.
Эта лаборатория существовала еще в советское время, тогда она называлась "противочумной станцией". Теперь это подразделение Национального центра по контролю над заболеваниями и общественного здоровья Грузии.
"Просто мы сейчас находимся в гораздо лучших условиях, гораздо безопаснее занимаемся тем, чем занимались все эти годы, начиная еще с далекого 1937-го года", – говорит Паата Имнадзе, руководитель центра Лугара.
Главная функция центра – обеспечение санитарно-эпидемиологической безопасности Грузии. Именно поэтому здесь хранится внушительная коллекция микроорганизмов: вирусов и бактерий, возбудителей различных заболеваний.
Все патогены в лаборатории Лугара – эндемические, то есть в разное время были распространены на территории Грузии, объясняют специалисты. Завозить вирусы из других стран даже с целью исследования не позволяет третий уровень безопасности лаборатории. Центры с максимальным, четвертым уровнем, где можно это делать, на постсоветском пространстве существуют только в двух странах: в России и Беларуси.
В 90-е годы коллекция вирусов была разбросана по разным лабораториям Грузии. Это было небезопасно, подчеркивают специалисты. Теперь вирусы и бактерии хранятся в одном месте.
"Я здесь, поскольку у меня есть опыт в области микробиологии и работы с различными исследовательскими группами. Я помогаю грузинским ученым налаживать контакты, знакомлю их с новыми возможностями и исследованиями, проведенными в США", – говорит микробиолог Майкл Вашингтон, который приехал в Грузию полтора года назад
Майкл Вашингтон – один из девяти американских специалистов в центре Лугара, он представляет американский Армейский научно-исследовательский институт имени Уолтера Рида.
Майкл говорит, что обвинения российской стороны "полностью фальшивы": возможности, а, главное, цели лаборатории Лугара далеко не те, чтобы кому-то угрожать.
"Это лаборатория общественного здравоохранения. И мы здесь работаем для того, чтобы способствовать улучшению здравоохранения в мире, выявляем и совершенствуем способы лечения и профилактики заболеваний, – говорит Вашингтон. – Наша работа носит чисто научный характер и полностью безопасна".
Граждане США – не единственные зарубежные специалисты лаборатории: в разное время здесь работали сотрудники из Европы, Турции, постсоветских стран и даже России.
"Наше заведение не очень-то и закрытое. Наоборот: для профессионалов оно очень даже открытое, – подчеркивает Паата Имнадзе. – И Грузия под эгидой Конвенции о запрещении биологического оружия даже официально пригласила комиссариат этой организации, провела что-то вроде инспекции. И, конечно же, российская сторона была тоже приглашена. Просим всех приехать, посмотреть, чем мы занимаемся. Скрывать нам нечего".